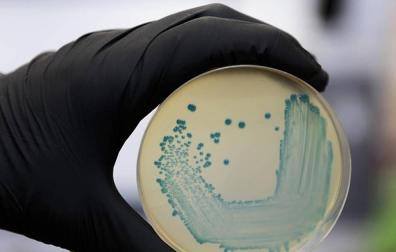
Imagen de un cultivo de la bacteria listeria.

3.797 inspecciones en Navarra para evitar intoxicaciones alimentarias
No se han detectado casos en Navarra de personas afectadas por los brotes de listeriosis y botulismo de los últimos días


Publicado el 03/09/2019 a las 19:30
Navarra cuenta con una amplia red y sistema de control oficial de establecimientos alimentarios coordinada por el Instituto de Salud Pública y Laboral de Navarra (ISPLN) y encaminada a evitar brotes como los recientemente generados en Andalucía, con la Listeria, y en Castilla y León, con un lote de atún enlatado contaminado con una toxina botulínica. Estos controles permiten actuar de una forma rápida y eficaz cuando se detectan situaciones de riesgo que pudieran producir casos de enfermedad. Así, durante 2018 se realizaron 3.797 inspecciones y se intervino en 56 alertas alimentarias.
Según Raúl González, jefe de la Sección de Seguridad Alimentaria del ISPLN, cuentan actualmente con 56 técnicos dedicados a la inspección, que permiten asegurar el control de todos los establecimientos alimentarios de la Comunidad Foral (a excepción de los ubicados en los términos municipales de Pamplona / Iruña y Tudela, que disponen de personal propio que realiza los controles, al tener sendos ayuntamientos delegadas las competencias en materia de seguridad alimentaria).
Tal y como se recoge en la Memoria de 2018 del ISPLN, desde la Sección de Seguridad Alimentaria se realizaron 3.797 inspecciones durante dicho periodo y se recogieron para su análisis 1.028 muestras de alimentos, en las que se realizaron distintos tipos de análisis como microbiológicos, de aditivos, de contaminantes, de plaguicidas, de alérgenos, de organismos modificados genéticamente (OMG’s), entre otros. Concretamente, para la bacteria de la listeria (Listeria monocytogenes), se analizaron 125 muestras de alimentos y se participó en un estudio coordinado por la Agencia Españolade Seguridad Alimentaria y Nutrición (AESAN) para su determinación en vegetales congelados.
SISTEMA DE ALERTAS
En cuanto a las alertas alimentarias, Navarra está integrada en el sistema estatal de alertas alimentarias coordinado por la AESAN, llamado SCIRI (Sistema Coordinado de Intercambio Rápido de Información). Este sistema mantiene a las comunidades autónomas informadas sobre cualquier tipo de riesgo detectado en alimentos en cualquier punto del Estado.
Te puede interesar
En cada territorio, la autoridad sanitaria competente, en el caso de Navarra la Sección de Seguridad Alimentaria del ISPLN, cuenta con un sistema de guardia específico que recibe el aviso y reacciona de inmediato en caso de que una alerta afecte a la población de la Comunidad Foral.
El protocolo de alertas alimentarias incluye las siguientes actuaciones: visita urgente al establecimiento elaborador o distribuidor del producto; investigación de las causas de riesgo que han provocado la alerta; inmovilización en su caso del producto afectado presente en dicho establecimiento; y, por último, la elaboración y comunicación de la lista de distribución de dicho producto que ha podido llegar a otros establecimientos.
Por último, se comunica al propio sistema SCIRI el resultado de las actuaciones citadas para conocimiento de todas las autoridades competentes. Si es necesario, se comunica al sistema de guardia de vigilancia de enfermedades del propio ISPLN, así como a los distintos servicios implicados del Departamento de Salud.
En 2018 llegaron a través del Sistema SCIRI 256 alertas alimentarias y se intervino en 56 de ellas, por afectar en alguna medida a Navarra. En 2019 y hasta el momento, el número de alertas sanitarias comunicadas a nivel nacional asciende a 208, de las cuales Navarra ha intervenido en 25. La última alerta sanitaria de especial relevancia que afectó a la Comunidad Foral está vinculada a la intoxicación botulínica por consumo de atún en aceite de girasol de la marca DIA. Concretamente, el producto implicado corresponde a una conserva de formato RO 900, de la marca DIA, con lote 19/154 023 02587 elaborado en Frinsa del Noroeste S.A., con fecha de consumo preferente 31/12/2022.
Te puede interesar

RECOMENDACIONES
Desde el ISPLN se suman a las recomendaciones realizadas por la AESAN, dependiente del Ministerio de Sanidad, Consumo y Bienestar Social. La agencia estatal recoge en su página web un resumen sobre la Listeria y consejos de seguridad alimentaria para los consumidores, como puede ser la de mantener baja la temperatura de los frigoríficos en los hogares para limitar, así, el crecimiento potencial de bacterias.
SIN AFECCIÓN EN NAVARRA
Por otro lado, el ISPLN reitera que no ha registrado ningún caso relacionado con el brote de Listeria, surgido a principios de este mes de agosto en Andalucía, ni por el relacionado con el lote de atún enlatado y contaminado con una toxina botulínica. Además, los Servicios de Urgencias y Atención Primaria del Servicio Navarro de Salud-Osasunbidea no han atendido a pacientes relacionados directamente con ambos brotes de intoxicación alimentaria. La red sanitaria navarra continúa en alerta y siguiendo todos los protocolos trasladados desde el ISPLN, en conexión con otras autoridades del Estado y comunidades autónomas.
Manteniendo la máxima prudencia –debido a que el periodo de incubación de la listeriosis es de hasta 70 días y el del botulismo de hasta 8 días- Salud Pública insiste en trasladar a la población navarra un mensaje de tranquilidad y confianza en todas las medidas previas de seguridad alimentaria, así como en el sistema de vigilancia de salud pública y de asistencia sanitaria.